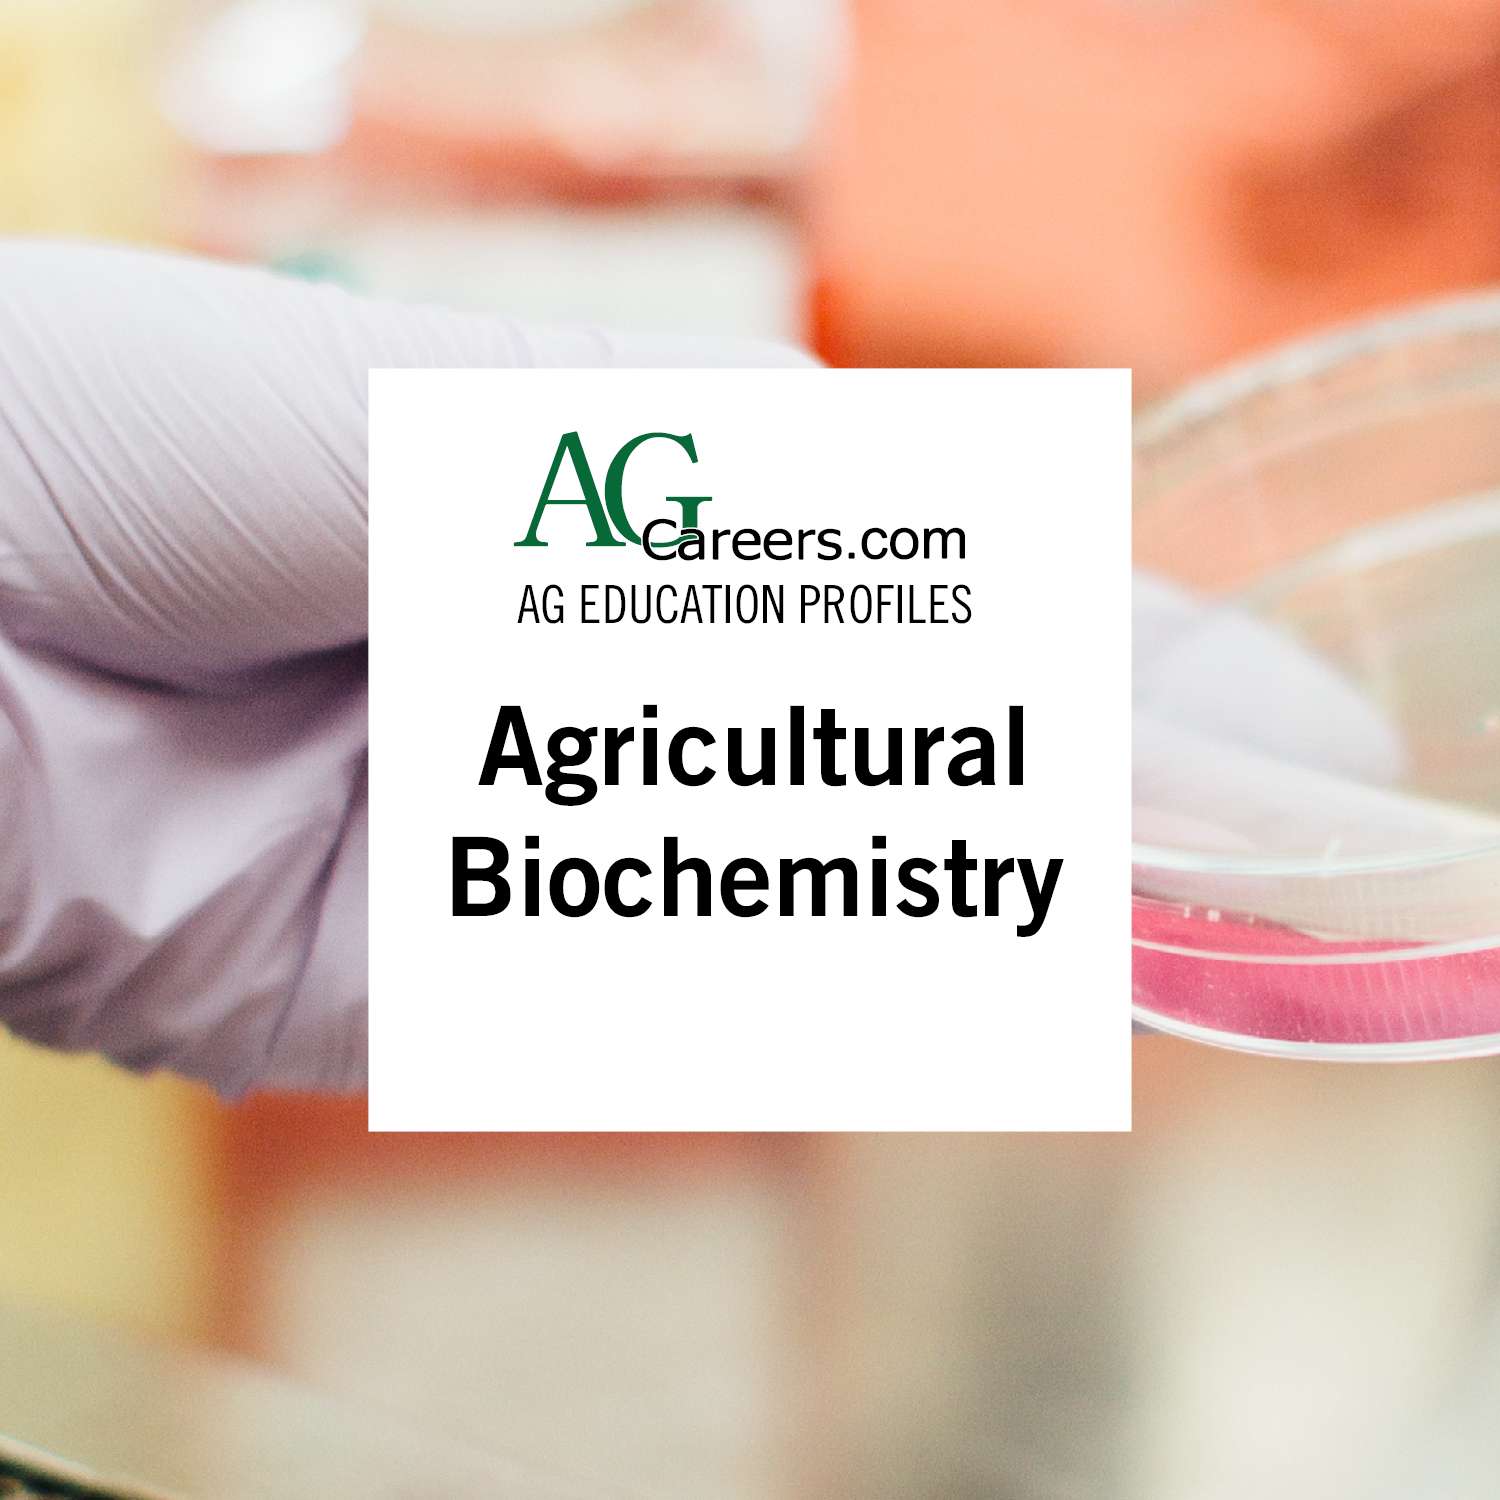

| Search jobs! |
|
Other/Related Variations
Degree Type/Duration
Overview
Students will explore both chemical and physical principles of life processes. Research and laboratory work, including analyzing data and preparing scientific reports, is common to help students understand biology. Biochemistry helps provide a basis for much of modern biotechnology.
Coursework may cover the following areas: Biochemistry, Nucleic Acids, Biological Systems, Research, Bioenergetics and Metabolism, Chemistry, Physics, Genetics, Mathematics, Statistics, Procaryotic Diversity and Ecology, Microbial Physiology, Biophysics, Bioenergetics, Immunology, Kinetics
Concentrations/Options
Potential Career Paths
Additional Opportunities/Recommendations